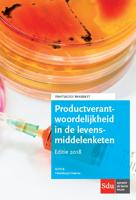
Productverantwoordelijkheid in de levensmiddelenketen - Heereluurt Heeres - Paperback (9789012402118)

De (pro)actieve patroon - Christ'l Dullaert - eBook (9789012392587)
Het opleiden van net afgestuurde juristen tot volwaardige advocaten, is een heel belangrijk thema en de rol voor de patroon is daarbij van groot belang. Met dit boek in de hand kan de (aankomend) patroon zijn aansturing van de stagiaire voorbereiden, onderbouwen en verfijnen. Het goed opleiden van jonge juristen is niet alleen belangrijk om het beste uit de jurist te halen maar het is ook een investering in de toekomst van het kantoor en in de kwaliteit van de dienstverlening. In deze tweede geheel herziene druk krijgen patroons en iedereen die leiding geeft aan jonge juristen praktische tips en achtergrondinformatie over het succesvol begeleiden en opleiden van advocaten en jonge juristen. Christl Dullaert is directeur van Le Tableau B.V., een bureau voor interim-advocaten en kandidaat-notarissen, training en advies. Met coauteur Monique van de Griendt schreef zij de boeken: De lastige partner: management van een advocatenkantoor en De ondernemende advocaat. Haar laatste boek Yoga in …
28,76